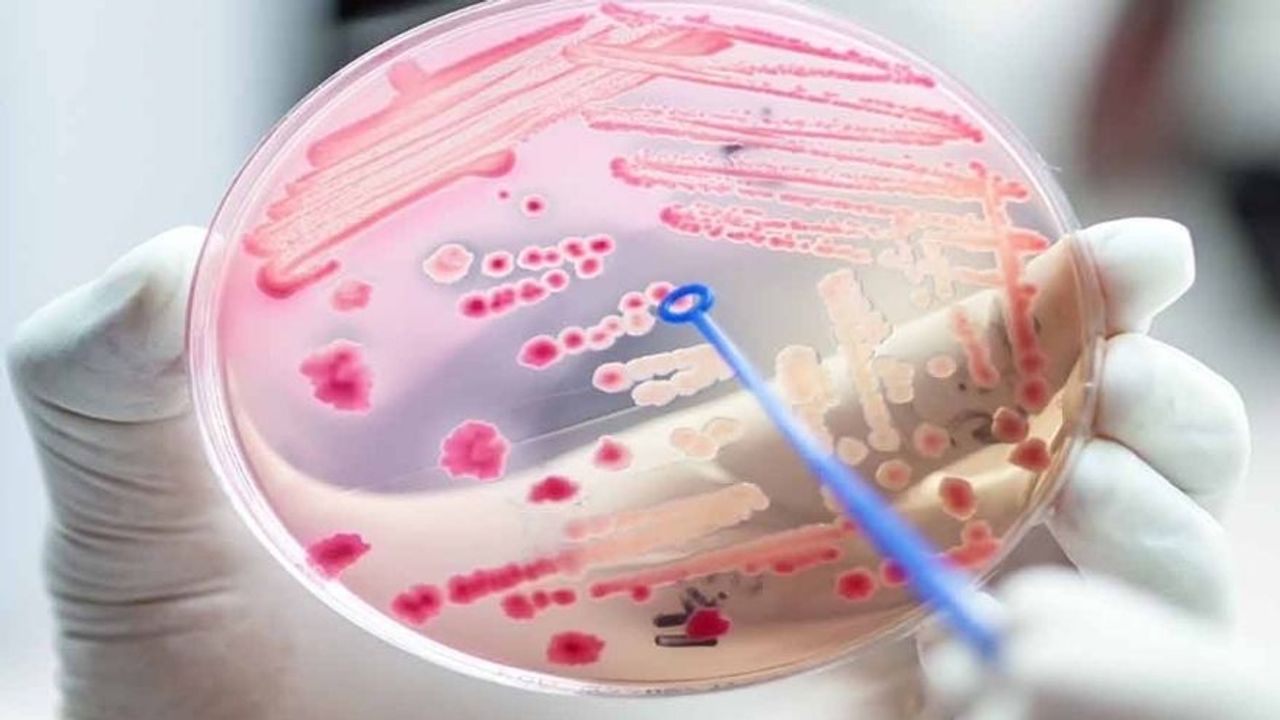

Sepsis; bakteri, virüs, mantar ya da parazit kaynaklı bir enfeksiyonun, vücudun genel savunma mekanizmasını bozarak organlara zarar vermesi sonucu ortaya çıkan hayati bir durumdur. Halk arasında sıkça ‘kan zehirlenmesi’ olarak bilinse de, sepsis yalnızca kanda mikrop bulunmasıyla sınırlı değildir. Asıl tehlike, bağışıklık sisteminin aşırı ve kontrolsüz yanıtıdır.
Sepsis, bağışıklık sisteminin kontrolden çıkarak kendi dokularına zarar verdiği, dakikaların bile çok değerli olduğu bir acil durumdur. Ateş, titreme ya da geçmeyen halsizlik gibi işaretler bazen vücudun enfeksiyona verdiği ağır bir yanıtın habercisi olabilmektedir.
Sepsis Neden ve Nasıl Gelişir?
Sepsis genellikle akciğer, idrar yolları, cilt, karın içi ya da kan dolaşımı kaynaklı enfeksiyonların ardından gelişir. Enfeksiyon ilerledikçe bağışıklık sistemi fazlasıyla aktive olur. Bu durum damar yapısında bozulmaya, tansiyon düşüklüğüne ve organlara yeterli oksijen gitmemesine yol açar. Müdahale geciktiğinde tablo ‘septik şok’ adı verilen en ağır evreye ilerleyebilir.

Sepsis Belirtileri Nelerdir?
Sepsis, her hastada farklı belirtilerle ortaya çıkabilir fakat en sık görülen işaretler şunlardır:
· Yüksek ateş ya da tam tersine ani ısı düşüklüğü
· Şiddetli titreme ve üşüme
· Hızlı nefes alıp verme
· Kalp atışında belirgin hızlanma
· Bilinç bulanıklığı, sersemlik
· İdrar miktarında azalma
· Ciltte solukluk ya da morarma
Nasıl Tanı Konulur?
Sepsis tanısı; hastanın klinik bulguları, kan testleri, enfeksiyon odağının saptanması ve organ fonksiyonlarını gösteren laboratuvar değerleriyle konulur. Erken tanı, tedavinin başarısını doğrudan belirleyen en kritik faktördür.

Sepsis Tedavisi Nasıldır?
Sepsis tedavisi hastane ortamında, çoğu zaman yoğun bakım koşullarında yürütülür. Tedavinin temelini:
· Hızlı antibiyotik başlanması
· Damar yoluyla sıvı desteği
· Gerekli durumlarda solunum ve dolaşım desteği oluşturur.
Sepsis Önlenebilir Mi?
Sepsisten korunmanın en etkili yolu, enfeksiyonların erken dönemde ciddiyetle ele alınmasıdır. Aşıların düzenli yapılması, hijyen kurallarına uyulması, kronik hastalıkların iyi yönetilmesi ve ameliyat sonrası bakımın aksatılmaması sepsis riskini önemli ölçüde azaltır.
Kimler Daha Yüksek Risk Altında?
Sepsis herkesi etkileyebilir fakat bazı gruplarda risk çok daha yüksektir. Yeni doğanlar, 65 yaş üzerindeki bireyler, bağışıklık sistemi baskılanmış hastalar, diyabet ve kanser hastaları ile büyük cerrahi operasyon geçirenler sepsis açısından daha yakından izlenmelidir.